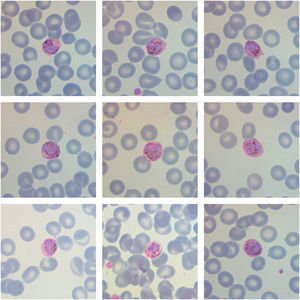

Rapid diagnostic tests for malaria as well as thick film performed upon arrival were negative. A peripheral blood film stained with May-Grünwald and Giemsa showed slightly enlarged red blood cells covered with Schüffner's dots and prominent brown pigment (hemozoin), suggesting infection by plasmodium at the gametocyte stage. The results obtained by quantitative polymerase chain reaction (qPCR) later on confirmed infection by Plasmodium ovale.
Malaria is a parasite infection caused by Plasmodium spp. Traditionally considered the rarest species, in recent years a rise in cases associated with P. ovale has been observed. Trophozoites are the most common morphological finding however, after a long incubation period of this species, gametocytes may be found. 1 Stippling is more pronounced and tends to darken the red blood cell. As P. ovale exclusively infects reticulocytes, the parasite density is typically low.2P. ovale is endemic in western Africa and the Southwest Pacific. The increase in migration flows underscores the need for an early microscopic identification of this infection, in order to achieve a swift diagnosis and guarantee correct treatment.